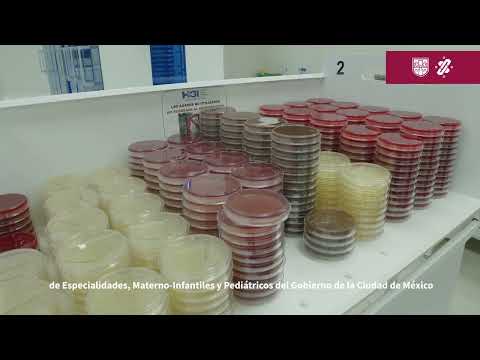

Modelo de Atención Temprana del paciente Covid-19. Hospital General Ajusco Medio.
Publicado el 18 Agosto 2020
Modelo de Atención Temprana del paciente Covid-19. Hospital General Ajusco Medio.
Compartir
Imprimir